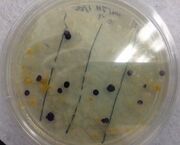

Uploads by Justyne Hindley
From OpenWetWare
Jump to navigationJump to search
This special page shows all uploaded files.
| Date | Name | Thumbnail | Size | Description |
|---|---|---|---|---|
| 01:09, 18 March 2016 | Screenshot (131).jpg (file) |  |
32 KB | |
| 01:44, 4 March 2016 | IMG 7522.jpg (file) |  |
23 KB | |
| 13:54, 26 February 2016 | Dr. H.G..jpg (file) |  |
360 KB | |
| 13:54, 26 February 2016 | Termites rush.jpg (file) |  |
276 KB | |
| 13:53, 26 February 2016 | Annelid worm.jpg (file) |  |
567 KB | |
| 13:49, 26 February 2016 | Screenshot (111).jpg (file) | 16 KB | ||
| 04:48, 26 February 2016 | Screenshot (110).jpg (file) | 15 KB | ||
| 04:26, 26 February 2016 | IMG 7635.jpg (file) |  |
25 KB | |
| 13:32, 12 February 2016 | IMG 7545.jpg (file) |  |
30 KB | |
| 13:31, 12 February 2016 | IMG 7546.jpg (file) |  |
35 KB | |
| 21:58, 10 February 2016 | IMG 7464 (1).jpg (file) |  |
39 KB | |
| 21:58, 10 February 2016 | IMG 7463 (1).jpg (file) | |
41 KB | |
| 21:57, 10 February 2016 | IMG 7467 (1).jpg (file) |  |
42 KB | |
| 21:57, 10 February 2016 | IMG 7465 (1).jpg (file) |  |
39 KB | |
| 21:35, 10 February 2016 | IMG 7542.jpg (file) |  |
28 KB | |
| 21:35, 10 February 2016 | IMG 7541.jpg (file) |  |
31 KB | |
| 21:14, 10 February 2016 | IMG 7540.jpg (file) |  |
27 KB | |
| 21:13, 10 February 2016 | IMG 7538.jpg (file) |  |
25 KB | |
| 21:13, 10 February 2016 | IMG 7536.jpg (file) |  |
28 KB | |
| 21:11, 10 February 2016 | IMG 7537.jpg (file) |  |
31 KB | |
| 21:10, 10 February 2016 | IMG 7520.jpg (file) |  |
38 KB | |
| 04:52, 10 February 2016 | Screenshot (92).jpg (file) |  |
39 KB | |
| 04:33, 10 February 2016 | Screenshot (88).jpg (file) |  |
51 KB | |
| 19:51, 1 February 2016 | Screenshot (84).jpg (file) |  |
51 KB | |
| 19:22, 1 February 2016 | Screenshot(83).jpg (file) |  |
30 KB | |
| 22:08, 24 January 2016 | FullSizeRender (7).jpg (file) |  |
58 KB | |
| 21:35, 24 January 2016 | FullSizeRender (5).jpg (file) |  |
69 KB | |
| 21:35, 24 January 2016 | FullSizeRender (4).jpg (file) |  |
47 KB | |
| 21:31, 24 January 2016 | FullSizeRender(1).jpg (file) |  |
476 KB | |
| 15:42, 15 January 2016 | IMG 7253.jpg (file) |  |
167 KB | NW edge of transect |
| 15:41, 15 January 2016 | IMG 7254.jpg (file) |  |
109 KB | Transect- Dirt next to walking path at ending point of transect |
| 15:39, 15 January 2016 | IMG 7255.jpg (file) |  |
123 KB | Transect- Dirt next to walking path |
| 15:38, 15 January 2016 | IMG 7256.jpg (file) |  |
125 KB | Panoramic of transect |
| 15:30, 15 January 2016 | IMG 7258.jpg (file) |  |
181 KB | Arial Transect |